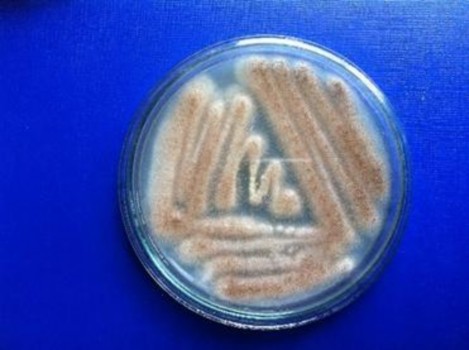
Hình 3 1 Chủng nấm sợi Aspergillus niger GA15 Hình 3 2 Kiểm tra hoạt tính enzyme 3

146. Vu V. H., Pham T. A. & Kim K. (2010). Improvement of a fungal strain by repeated and sequential mutagenesis and optimization of solid-state fermentation for the hyper-production of raw-starch-digesting enzyme. Journal of Microbiology and Biotechnology. 20(4): 718-726.
147. Vu V. H., Pham T. A. & Kim K. (2011). Improvement of fungal cellulase production by mutation and optimization of solid state fermentation. Mycobiology. 39(1): 20-25.
148. Vu V. H., Pham T. A., & Kim K. (2009). Fungal strain improvement for cellulase production using repeated and sequential mutagenesis. Mycobiology. 37(4): 267- 271.
149. Wang C., Shi C., Zhang Y., Song D., Lu Z. & Wang Y. (2018). Microbiota in fermented feed and swine gut. Applied Microbiology and Biotechnology. 102(7): 2941-2948.
150. Warner R. D., Kauffman R. G. & Greaser M. L. (1997). Muscle protein changes post mortem in relation to pork quality traits. Meat Science. 45(3): 339-352.
151. Wenk C. (2000). Recent advances in animal feed additives such as metabolic modifiers, antimicrobial agents, probiotics, enzymes and highly available minerals- review. Asian-Australasian Journal of Animal Sciences. 13(1): 86-95.
152. Wu Q. J., Wang Z. B., Wang G. Y., Li Y. X. & Qi Y. X. (2015). Effects of feed supplemented with fermented pine needles (Pinus ponderosa) on growth performance and antioxidant status in broilers. Poultry Science. 94(6): 1138-1144.
153. Yamamoto M., Saleh F., Tahir M., Ohtsuka A. & Hayashi K. (2007). The effect of Koji-feed (fermented distillery by-product) on the growth performance and nutrient metabolizability in broiler. The Journal of Poultry Science. 44(3): 291-296.
154. Yang H., Qu Y., Li J., Liu X., Wu R. & Wu, J. (2020). Improvement of the protein quality and degradation of allergens in soybean meal by combination fermentation and enzymatic hydrolysis. Lwt. 128: 109442.
155. Zambare V. (2010). Solid state fermentation of Aspergillus oryzae for glucoamylase production on agro residues. International Journal of life sciences. 4: 16-25.
156. Zhao P.C., Xia J. & Deng Y.W. (2014). UV and 60 Co-γ-ray combined mutagenesis of Aspergillus niger for the enhancement of glucoamylase activity. Mycosystema. 33: 1-7.
157. Ziaei-Nejad S., Rezaei M. H., Takami G. A., Lovett D. L., Mirvaghefi A.-R. & Shakouri M. (2006). The effect of Bacillus spp. bacteria used as probiotics on digestive enzyme activity, survival and growth in the Indian white shrimp Fenneropenaeus indicus. Aquaculture. 252(2-4): 516-524.
PHỤ LỤC 1
Bảng 1.1. Xây dựng đường chuẩn glucose
1 | 2 | 3 | 4 | 5 | 6 | |
Nồng độ glucose (µM) | 0 | 1111.11 | 2222.22 | 3333.33 | 4444.44 | 5555.56 |
Dung dich glucose chuẩn (µl) | 0 | 20 | 40 | 60 | 80 | 100 |
Nước cất (µl) | 100 | 80 | 60 | 40 | 20 | 0 |
DNS (µl) | 100 | 100 | 100 | 100 | 100 | 100 |
Lắc đều, đem đun cách thủy trong 5 phút, để nguội ở nhiệt độ phòng | ||||||
Nước cất (µl) | 800 | 800 | 800 | 800 | 800 | 800 |
Có thể bạn quan tâm!
-
Ảnh Hưởng Tương Tác Giữa Khẩu Phần Với Các Mức Sử Dụng Bslm Và Tính Biệt Đến Năng Suất Thân Thịt (Lsm) Của Lợn F1(Landracexyorkshire) -
Nghiên cứu phát triển chủng nấm sợi và tối ưu điều kiện lên men sản xuất đa enzyme α-amylase, glucoamylase, cellulase ứng dụng trong chế biến thức ăn chăn nuôi - 14 -
Nghiên cứu phát triển chủng nấm sợi và tối ưu điều kiện lên men sản xuất đa enzyme α-amylase, glucoamylase, cellulase ứng dụng trong chế biến thức ăn chăn nuôi - 15 -
Một Số Hình Ảnh Của Quá Trình Lên Men Qui Mô Pilot. -
Nghiên cứu phát triển chủng nấm sợi và tối ưu điều kiện lên men sản xuất đa enzyme α-amylase, glucoamylase, cellulase ứng dụng trong chế biến thức ăn chăn nuôi - 18 -
Nghiên cứu phát triển chủng nấm sợi và tối ưu điều kiện lên men sản xuất đa enzyme α-amylase, glucoamylase, cellulase ứng dụng trong chế biến thức ăn chăn nuôi - 19
Xem toàn bộ 197 trang tài liệu này.
Bảng 1.2. Xây dựng đường chuẩn maltose
0 | 1 | 2 | 3 | 4 | 5 | |
Nồng độ maltose (µM) | 0 | 584.80 | 1169.59 | 1754.39 | 2339.18 | 2923.98 |
Nước cất (µl) | 100 | 80 | 60 | 40 | 20 | 0 |
DNS(µl) | 100 | 100 | 100 | 100 | 100 | 100 |
Lắc đều, đem đun cách thủy trong 5 phút, để nguội ở nhiệt độ phòng | ||||||
Nước cất(µl) | 800 | 800 | 800 | 800 | 800 | 800 |
Bảng 1.3. Thành phần hóa học của nguyên liệu thức ăn
Nguyên liệu | Vật chất khô (%) | Protein thô (%) | Lipit thô (%) | Xơ thô (%) | Khoáng tổng số (%) | Canxi (%) | Photpho (%) | |
1 | Ngô hạt | 88,11 | 9,27 | 4,21 | 3,05 | 1,50 | 0,09 | 0,15 |
2 | Cám mì | 87,69 | 14,71 | 4,30 | 9,85 | 4,29 | 0,13 | 0,89 |
3 | Khô đỗ | 84,45 | 42,57 | 7,40 | 5,86 | 5,97 | 0,26 | 0,67 |
4 | Bột cá nhạt | 88,98 | 51,58 | 10,52 | 2,97 | 22,54 | 4,34 | 3,01 |
5 | BSLM | 10,65 | 16,02 | 0,61 | 15,01 | 7,38 | 0,35 | 1,7 |
Bảng 1.4: Thành phần của Premix khoáng (trong 1kg Premix)
ĐVT | Hàm lượng | |
ZnSO4 (min‐max) | mg | 1500-1800 |
FeSO4 (min‐max) | mg | 1500-1800 |
MnSO4 (min‐max) | mg | 750-800 |
CuSO4 (min‐max) | mg | 250-300 |
Biotin | mg | 1,25 |
Cát sạn (max) | % | 2 |
Độ ẩm (max) | % | 10 |
PHỤ LỤC 2
ĐỊNH LOẠI SINH HỌC PHÂN TỬ CHỦNG A45.1

Hình 2.1. Trình tự 18S của chủng nấm sợiAsergillus niger A45.1

Hình 2.2. Cây phát sinh chủng loại của chủng nấm sợi A45.1 và các trình tự tương đồng
Chú thích: Chủng A45.1 có chung nguồn gốc phát sinh với 15 chủng nấm Aspergillus có trình tự xác định trên Genbank. Do đó có thể khẳng định chủng A45.1 là một chủng vi nấm thuộc chi Aspergillus, loài niger. Kết quả so sánh trình tự và phân tích bằng cây chủng loại phát sinh đã cho thấy A45.1 thuộc Aspergillus niger có trình tự có độ tương đồng cao (99%) và quan hệ họ hàng gần gũi với chủng Aspergillus niger HP2A với mã số KJ677240.1. Dựa trên kết quả so sánh về mặt di truyền của chủng nấm sợi A45.1, đặt tên A45.1 là A.niger A45.1.
PHỤ LỤC 3
MỘT SỐ HÌNH ẢNH TRONG QUÁ TRÌNH THỰC HIỆN ĐỀ TÀI
Hình 3.2: Kiểm tra hoạt tính enzyme α-amylase của chủng Aspergillus niger GA15) (1: Ống test, 2: Ống blank) |

Hình 3.3: Tối ưu nồng độ enzyme
Hình 3.4. Chế phẩm đa enzyme thô |
|
Hình 3.6. Lợn F1 (LY) ở lô TN2 |
Hình 3.7. Lợn F1 (LY) ở lô ĐC |
PHỤ LỤC 4
QUY TRÌNH SẢN XUẤT ĐA ENZYME QUY MÔ PILOT
1. Nguyên liệu
Hóa chất: HCl, DNS, ure, glycerol, NaCl, glucose, cồn….
Thiết bị thí nghiệm: Đèn cồn, dao cấy, que trải, ống eppendorf, ống đong, đĩa Petri, pipette, đầu tip.
Thiết bị lên men: Khay inox, khay nhựa, thau nhôm, bình tam giác 250ml, 1 lít, 3 lít, túi nilon chịu nhiệt 25x35, túi thiếc 25x35. Thau nhôm, khay nhựa, khay inox… Đem khử trùng và để nguội các dụng cụ này trước khi cấy giống.
Máy móc: Tủ cấy vô trùng, máy lắc, tủ sấy, máy trộn (mixxer), máy sealer (máy hàn miệng túi dập tay), máy đo pH, tủ lạnh sâu -860C.
Nguyên liệu khác: Cám mì, khoai tây, agar, nước, …
Thông số của các thiết bị:
Tủ cấy vô trùng: ESCO Class II Safety Cabinet
Máy lắc: Máy lắc tròn Model: HY-5, xuất xứ Trung Quốc
Tủ sấy: Model 101-1, xuất xứ Trung Quốc
Máy trộn (mixxer)
Máy sealer: Model PFS-300
Máy đo pH: HANNA HI 2211 PH/ORP Meter, xuất xứ Ý